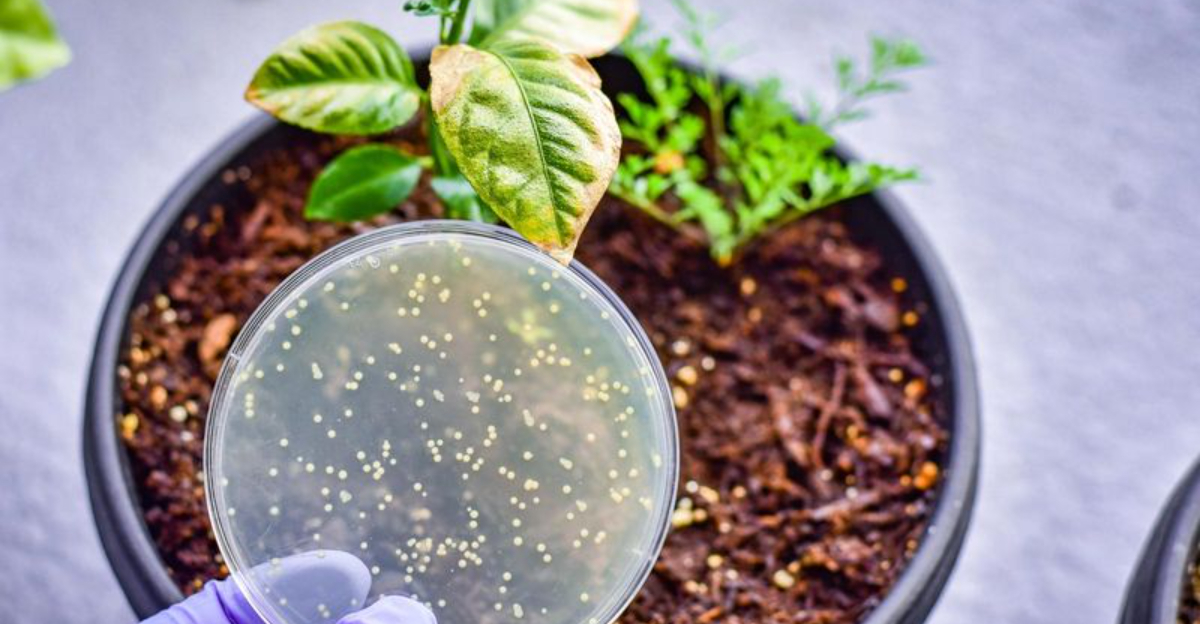

Soil might look like plain old dirt, but there’s way more going on beneath the surface. It’s a rich, living mix that plays a crucial role in keeping our planet—and everything on it—alive and thriving.
In this post, we’re digging into the science of soil: what it’s made of, how it forms, and why it matters more than you might think.
From tiny microbes to ancient minerals, let’s uncover the hidden world that makes soil one of nature’s unsung heroes.
1. Soil Color Varieties
Have you ever noticed the kaleidoscope of colors that soil can display? From the fiery reds of iron-rich soils to the deep, dark hues of humus-laden earth, soil color can tell us a lot about its composition and fertility. This vibrant palette is not just for show; it indicates the presence of various minerals and organic matter.
The color of soil is influenced by its mineral content and the organic materials it contains. For instance, soils rich in iron oxides often appear red or yellow, while those abundant in organic matter may take on a darker hue.
These differences can significantly affect the soil’s ability to support plant life, making color a valuable indicator for farmers and gardeners alike.
Consider a walk through different landscapes, and you’ll see the earth painting a picture in shades of brown, yellow, and even purple. This diversity is a testament to the dynamic processes that shape our planet’s surface.
2. Texture and Feel
The texture of soil is like a silent storyteller, whispering tales of its journey and composition. Whether it’s the gritty feel of sandy soil sliding through your fingers or the sticky grasp of clay, each texture offers unique qualities for plant growth.
Soil texture is determined by the proportions of sand, silt, and clay it contains. Sandy soils, with larger particles, drain quickly but often lack nutrients. In contrast, clayey soils retain moisture well but can be heavy and compacted. The ideal garden soil, known as loam, is a balanced mix of these components, offering both fertility and good drainage.
Have you ever sifted soil through your hands and felt the difference? This tactile interaction provides insights into how best to cultivate and care for the land.
3. Acid Sulfate Soils
In certain regions, soil can harbor a hidden menace: acid sulfate soils. Typically found in coastal and low-lying areas, these soils contain iron sulfides that, when exposed to air through drainage or excavation, oxidize and produce sulfuric acid.
This chemical reaction can lead to severe environmental problems, including the acidification of waterways and damage to aquatic ecosystems. Farmers and land developers must manage these soils carefully to prevent such harmful effects.
Recognizing and mitigating the impact of acid sulfate soils is essential for sustainable land use, ensuring that both natural habitats and agricultural endeavors can thrive.
4. Air Spaces
Air spaces in soil are as important as its solid components. They allow oxygen to reach plant roots and microorganisms, crucial for respiration and nutrient uptake. The size and distribution of these spaces affect soil aeration and drainage.
Compacted soils have reduced air spaces, leading to poor root growth and decreased microbial activity. Practices like tilling and adding organic matter can enhance soil aeration.
Understanding the role of air spaces can lead to better soil management and healthier plant ecosystems, emphasizing the need to maintain soil structure for optimal air and water balance.
5. Soil Microorganisms
Soil teems with life, largely due to microorganisms like bacteria, fungi, and protozoa. These tiny organisms play crucial roles in nutrient cycling and organic matter decomposition, influencing soil health.
Bacteria break down complex organic materials, releasing nutrients essential for plant growth. Fungi, including mycorrhizal fungi, form symbiotic relationships with plant roots, aiding nutrient absorption.
Protozoa and nematodes help regulate microbial populations, ensuring a balanced ecosystem.
Understanding the role of soil microorganisms can aid in promoting soil fertility naturally, reducing reliance on chemical fertilizers and fostering sustainable agricultural practices.
6. Organic Matter
Organic matter infuses life into soil. It comprises decomposed plant material, animal residues, and microorganisms. This component enriches soil fertility by adding essential nutrients and enhancing its structure. Organic matter improves soil’s water retention and aeration, supporting healthy plant growth.
Decomposition processes, driven by bacteria and fungi, transform dead organic material into humus, a dark, nutrient-rich substance.
In gardening, adding compost is a practical way to boost organic content, encouraging robust plant development. By understanding organic matter’s role, we can harness its benefits, leading to healthier ecosystems and sustainable agriculture.
7. Soil Formation
Soil formation is a slow process driven by weathering and organic decomposition. It begins with the breakdown of rocks into mineral particles, enriched by organic matter from decomposing plants and animals. Climate, organisms, relief, parent material, and time (known as CLORPT) influence soil development.
Understanding soil formation helps in predicting soil behavior and managing land sustainably. Knowledge of these processes is crucial for agriculture, forestry, and land restoration.
By appreciating the factors shaping soil, we can make informed decisions that support ecological balance and resource conservation.
8. Water Content
Water content in soil is vital for plant growth. It affects nutrient availability, root development, and microbial activity. Different soils retain water differently; clay holds more moisture than sandy soil due to its finer particles.
However, excessive water can lead to poor aeration and root diseases. Proper water management ensures optimal plant growth and soil health.
Understanding soil’s water retention capacity helps in effective irrigation planning, enhancing agricultural productivity. By studying soil moisture dynamics, we can make informed decisions that support sustainable land and water use.
9. Soil pH Levels
Soil pH levels determine nutrient availability and microbial activity. A pH scale ranges from acidic (below 7) to alkaline (above 7). Most plants thrive in neutral to slightly acidic soils.
Extremely acidic or alkaline soils can limit nutrient uptake, affecting plant health. Adjusting soil pH involves adding lime to raise or sulfur to lower the pH.
Regular soil testing helps monitor pH levels, guiding amendments to maintain optimal conditions for plant growth. By understanding soil pH, gardeners and farmers can ensure their crops receive the necessary nutrients for healthy development.
10. Mineral Particles
Mineral particles are the backbone of soil structure. They come in various sizes, primarily categorized into sand, silt, and clay. Each type influences soil’s texture and water retention capabilities differently.
Sand particles are the largest, promoting drainage but offering little nutrient retention. Silt, being medium-sized, balances characteristics, providing moderate fertility and drainage. Clay particles are the smallest, holding water well but sometimes leading to poor drainage.
The mineral composition of soil originates from the weathering of rocks. Over time, rocks break down through physical and chemical processes, contributing essential minerals to the soil matrix.
11. Soil Horizons
Soil horizons are distinct layers that develop over time. These layers include the topsoil, subsoil, and parent material, each with unique properties. Topsoil is rich in organic matter, supporting most plant life. Subsoil contains minerals leached from above, providing a secondary nutrient source.
The parent material is the underlying geological layer, influencing soil texture and mineral content. Understanding these layers aids in soil management practices, such as proper fertilization and erosion control.
By exploring soil horizons, we gain insights into soil formation and its capacity to support diverse ecosystems.
12. Human Impact on Soil
Human activities significantly impact soil health. Urbanization, deforestation, and industrial agriculture contribute to soil degradation. These activities alter soil structure, reduce organic matter, and increase erosion risks.
Sustainable practices, such as reforestation, organic farming, and soil conservation techniques, help mitigate these effects. Understanding human impact on soil is essential for developing policies that protect soil resources.
By promoting practices that preserve soil health, we can ensure a sustainable future, balancing human needs with environmental stewardship. Recognizing our role in soil management empowers us to make responsible decisions for the planet.
13. Soil Erosion
Soil erosion is a natural process accelerated by human activities like deforestation and agriculture. It involves the removal of topsoil by wind or water, leading to loss of soil fertility and structure. Erosion can devastate agricultural lands, reducing productivity and increasing sediment in waterways.
Preventive measures include planting cover crops, building terraces, and practicing no-till farming. By understanding erosion processes, we can implement strategies to protect soil resources, promoting sustainable land management.
The fight against soil erosion is crucial for maintaining healthy ecosystems and ensuring food security for future generations.
14. Nutrient Cycling
Nutrient cycling in soil involves the transfer of nutrients between living organisms and the environment. This process is vital for maintaining soil fertility and ecosystem health. Plants absorb nutrients from the soil, which return to the earth through decomposing organic matter.
Microorganisms break down these materials, releasing nutrients back into the soil. Human practices, like crop rotation and organic fertilization, support nutrient cycling by maintaining soil health.
Understanding nutrient dynamics facilitates sustainable agricultural practices, reducing dependence on synthetic fertilizers and enhancing soil resilience. Nutrient cycling ensures long-term soil productivity and environmental balance.